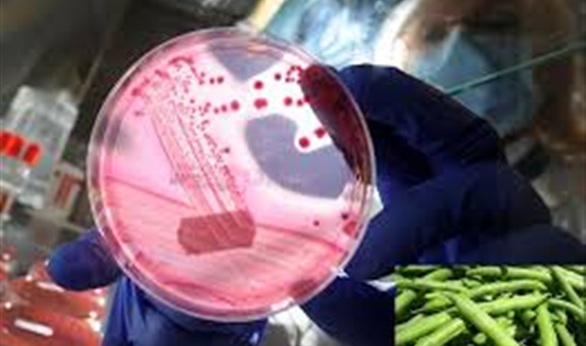

شركة (تشيبوتلي) تغلق فروعها في سياتل وبورترند بسبب التلوث الغذائي
أعلنت شركة (تشيبوتلي مكسيكان جريل) اغلاق جميع مطاعمها في سياتل وبورتلاند بالغرب الأمريكي بسبب تفشي تلوث بالبكتريا المعوية (إي كولاي) فيما تجري السلطات الصحية والشركة تحقيقات للوقوف على أسباب هذا التلوث.
وقالت الشركة في بيان "بعد تلقي بلاغات من مسؤولي ادارات الصحة في منطقتي سياتل بولاية واشنطن وبورتلاند بولاية أوريجون يجري التحري عن نحو 20 حالة اصابة بالبكتريا المعوية بمن في ذلك رواد ستة من مطاعمنا في المنطقتين وزيادة في الحرص أغلقنا على الفور جميع مطاعمنا بالمنطقة".
وقالت الشركة إن الغالبية العظمى من متاجرها بالمنطقة لم تبلغ عن أي مشاكل وأضافت "نعبر عن تعاطفنا العميق مع أولئك الذي أضيروا جراء هذا الوضع".
وهذا هو ثالث تفش للتلوث الغذائي بمطاعم الشركة منذ أغسطس آب الماضي وتضمنت حالات سابقة التسمم بالسالمونيلا وفيروس نوروفيروس الشديد العدوى.
وتضم الشركة 1700 منفذ ونمت أعمالها بسرعة منذ افتتاحها في عام 1993 بفرع وحيد وتصف نفسها بانها مطاعم نموذجية لوجبات سريعة تتميز بالمكونات الصحية الطازجة العالية الجودة في الاصناف التي تقدمها من البوريتوس والتاكوس وأنواع السلطات.
وثمة توجه متزايد بين المطاعم مثل (تشيبوتلي) لاستخدام الأغذية الطازجة غير المصنعة وهو الأمر السليم من ناحية التغذية لكن الخبراء يقولون إنه يثير مخاوف بشأن الكائنات الممرضة لان عمليات الطهي تقتل الميكروبات التي تنقل الأمراض.
تقول ادارة الصحة في أوريجون إن ثلاث حالات اصابة بالبكتريا المعوية في أوريجون و19 على الاقل في واشنطن ترتبط بمطاعم الشركة منذ 14 أكتوبر تشرين الاول الماضي وتتراوح أعمار المصابين بين 11 الى 64 عاما.
ونقل ثلث المصابين الى المستشفيات لكن لم تسجل أي حالات وفاة.
وقالت الادارة إن من المتوقع زيادة حالات الاصابة لان بعض من اصيبوا بالبكتريا لم يلجأوا الى مؤسسات الرعاية الصحية.
و(إي كولاي) ضمن مجموعة كبيرة من البكتريا التي تعيش في أمعاء الانسان دون ان تسبب له اي مشاكل بل انها تساهم في تخليق فيتامين (ب) لكن بعض السلالات يمكن ان تسبب أعراضا خطيرة منها ما يهدد الحياة وتنجم عن تناول اطعمة ملوثة.
وفي سياق متصل قال مسؤولون اتحاديون إن شركة لانتاج اللحوم في نبراسكا سحبت أكثر من 167 ألف رطل من منتجات لحوم الابقار للاشتباه في تلوثها بهذه البكتريا المعوية.
وقال بيان لهيئة التفتيش والأمن الغذائي بوزارة الزراعة الامريكية إنه لم ترد أي تقارير بعد تؤكد ارتباط هذه الاصابات باللحوم البقرية.أعلنت شركة (تشيبوتلي مكسيكان جريل) اغلاق جميع مطاعمها في سياتل وبورتلاند بالغرب الأمريكي بسبب تفشي تلوث بالبكتريا المعوية (إي كولاي) فيما تجري السلطات الصحية والشركة تحقيقات للوقوف على أسباب هذا التلوث.
وقالت الشركة في بيان "بعد تلقي بلاغات من مسؤولي ادارات الصحة في منطقتي سياتل بولاية واشنطن وبورتلاند بولاية أوريجون يجري التحري عن نحو 20 حالة اصابة بالبكتريا المعوية بمن في ذلك رواد ستة من مطاعمنا في المنطقتين وزيادة في الحرص أغلقنا على الفور جميع مطاعمنا بالمنطقة".
وقالت الشركة إن الغالبية العظمى من متاجرها بالمنطقة لم تبلغ عن أي مشاكل وأضافت "نعبر عن تعاطفنا العميق مع أولئك الذي أضيروا جراء هذا الوضع".
وهذا هو ثالث تفش للتلوث الغذائي بمطاعم الشركة منذ أغسطس آب الماضي وتضمنت حالات سابقة التسمم بالسالمونيلا وفيروس نوروفيروس الشديد العدوى.
وتضم الشركة 1700 منفذ ونمت أعمالها بسرعة منذ افتتاحها في عام 1993 بفرع وحيد وتصف نفسها بانها مطاعم نموذجية لوجبات سريعة تتميز بالمكونات الصحية الطازجة العالية الجودة في الاصناف التي تقدمها من البوريتوس والتاكوس وأنواع السلطات.
وثمة توجه متزايد بين المطاعم مثل (تشيبوتلي) لاستخدام الأغذية الطازجة غير المصنعة وهو الأمر السليم من ناحية التغذية لكن الخبراء يقولون إنه يثير مخاوف بشأن الكائنات الممرضة لان عمليات الطهي تقتل الميكروبات التي تنقل الأمراض.
تقول ادارة الصحة في أوريجون إن ثلاث حالات اصابة بالبكتريا المعوية في أوريجون و19 على الاقل في واشنطن ترتبط بمطاعم الشركة منذ 14 أكتوبر تشرين الاول الماضي وتتراوح أعمار المصابين بين 11 الى 64 عاما.
ونقل ثلث المصابين الى المستشفيات لكن لم تسجل أي حالات وفاة.
وقالت الادارة إن من المتوقع زيادة حالات الاصابة لان بعض من اصيبوا بالبكتريا لم يلجأوا الى مؤسسات الرعاية الصحية.
و(إي كولاي) ضمن مجموعة كبيرة من البكتريا التي تعيش في أمعاء الانسان دون ان تسبب له اي مشاكل بل انها تساهم في تخليق فيتامين (ب) لكن بعض السلالات يمكن ان تسبب أعراضا خطيرة منها ما يهدد الحياة وتنجم عن تناول اطعمة ملوثة.
وفي سياق متصل قال مسؤولون اتحاديون إن شركة لانتاج اللحوم في نبراسكا سحبت أكثر من 167 ألف رطل من منتجات لحوم الابقار للاشتباه في تلوثها بهذه البكتريا المعوية.
وقال بيان لهيئة التفتيش والأمن الغذائي بوزارة الزراعة الامريكية إنه لم ترد أي تقارير بعد تؤكد ارتباط هذه الاصابات باللحوم البقرية.






















